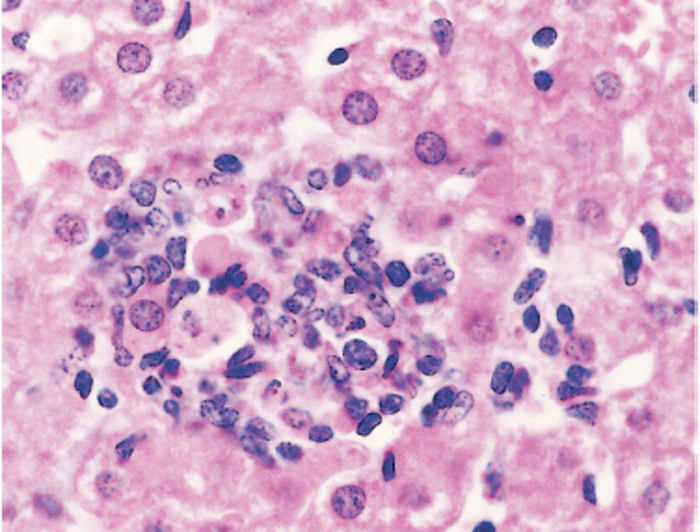

- Infectious Diseases of Livestock
- Part 2
- Wesselsbron disease
- GENERAL INTRODUCTION: PARAMYXOVIRIDAE AND PNEUMOVIRIDAE
- Rinderpest
- Peste des petits ruminants
- Parainfluenza type 3 infection
- Bovine respiratory syncytial virus infection
- Hendra virus infection
- Paramyxovirus-induced reproductive failure and congenital defects in pigs
- Nipah virus disease
- GENERAL INTRODUCTION: CALICIVIRIDAE AND ASTROVIRIDAE
- Vesicular exanthema
- Enteric caliciviruses of pigs and cattle
- GENERAL INTRODUCTION: RETROVIRIDAE
- Enzootic bovine leukosis
- Jaagsiekte
- Visna-maedi
- Caprine arthritis-encephalitis
- Equine infectious anaemia
- GENERAL INTRODUCTION: PAPILLOMAVIRIDAE
- Papillomavirus infection of ruminants
- Papillomavirus infection of equids
- GENERAL INTRODUCTION: ORTHOMYXOVIRIDAE
- Equine influenza
- Swine influenza
- GENERAL INTRODUCTION: CORONAVIRIDAE
- Porcine transmissible gastroenteritis
- Porcine respiratory coronavirus infection
- Porcine epidemic diarrhoea
- Porcine haemagglutinating encephalomyelitis virus infection
- Porcine deltacoronavirus infection
- Bovine coronavirus infection
- Ovine coronavirus infection
- Equine coronavirus infection
- GENERAL INTRODUCTION: PARVOVIRIDAE
- Porcine parvovirus infection
- Bovine parvovirus infection
- GENERAL INTRODUCTION: ADENOVIRIDAE
- Adenovirus infections
- GENERAL INTRODUCTION: HERPESVIRIDAE
- Equid herpesvirus 1 and equid herpesvirus 4 infections
- Equid gammaherpesvirus 2 and equid gammaherpesvirus 5 infections
- Equine coital exanthema
- Infectious bovine rhinotracheitis/infectious pustular vulvovaginitis and infectious pustular balanoposthitis
- Bovine alphaherpesvirus 2 infections
- Malignant catarrhal fever
- Pseudorabies
- Suid herpesvirus 2 infection
- GENERAL INTRODUCTION: ARTERIVIRIDAE
- Equine viral arteritis
- Porcine reproductive and respiratory syndrome
- GENERAL INTRODUCTION: FLAVIVIRIDAE
- Bovine viral diarrhoea and mucosal disease
- Border disease
- Hog cholera
- Wesselsbron disease
- Louping ill
- West nile virus infection
- GENERAL INTRODUCTION: TOGAVIRIDAE
- Equine encephalitides caused by alphaviruses in the Western Hemisphere
- Old World alphavirus infections in animals
- Getah virus infection
- GENERAL INTRODUCTION: BUNYAVIRIDAE
- Diseases caused by Akabane and related Simbu-group viruses
- Rift Valley fever
- Nairobi sheep disease
- Crimean-Congo haemorrhagic fever
- GENERAL INTRODUCTION: ASFARVIRIDAE
- African swine fever
- GENERAL INTRODUCTION: RHABDOVIRIDAE
- Rabies
- Bovine ephemeral fever
- Vesicular stomatitis and other vesiculovirus infections
- GENERAL INTRODUCTION: REOVIRIDAE
- Bluetongue
- Ibaraki disease in cattle
- Epizootic haemorrhagic disease
- African horse sickness
- Equine encephalosis
- Palyam serogroup orbivirus infections
- Rotavirus infections
- GENERAL INTRODUCTION: POXVIRIDAE
- Lumpy skin disease
- Sheeppox and goatpox
- Orf
- Ulcerative dermatosis
- Bovine papular stomatitis
- Pseudocowpox
- Swinepox
- Cowpox
- Horsepox
- Camelpox
- Buffalopox
- GENERAL INTRODUCTION: PICORNAVIRIDAE
- Teschen, Talfan and reproductive diseases caused by porcine enteroviruses
- Encephalomyocarditis virus infection
- Swine vesicular disease
- Equine picornavirus infection
- Bovine rhinovirus infection
- Foot-and-mouth disease
- GENERAL INTRODUCTION: BORNAVIRIDAE
- Borna disease
- GENERAL INTRODUCTION: CIRCOVIRIDAE AND ANELLOVIRIDAE
- Post-weaning multi-systemic wasting syndrome in swine
- GENERAL INTRODUCTION: PRION DISEASES
- Scrapie
- Bovine spongiform encephalopathy
- Transmissible spongiform encephalopathies related to bovine spongiform encephalopathy in other domestic and captive wild species
Wesselsbron disease
This content is distributed under the following licence: Attribution-NonCommercial CC BY-NC
View Creative Commons Licence details here

Wesselsbron disease
Previous authors: R SWANEPOEL AND J A W COETZER
Current authors:
M QUAN - Associate Professor, BVSc, MSc, PhD, Department of Veterinary Tropical Diseases, University of Pretoria, Room 2-18, Faculty of Veterinary Science, Gauteng, 0110, South Africa
JAW COETZER - Professor Emeritus, BVSc, BVSc (Hons), M Med Vet (Path), Department of Veterinary Tropical Diseases, Faculty of Veterinary Science, University of Pretoria, Private Bag X04, Onderstepoort, Pretoria, 0111, South Africa
R SWANEPOEL - Extraordinary Lecturer, BVSc, DTVM, PhD, Department of Veterinary Tropical Diseases, Faculty of Veterinary Science, University of Pretoria, Private Bag X04, Onderstepoort, Pretoria, 0111, South Africa
Introduction
Wesselsbron disease (WSL) is an acute arthropod-borne flavivirus infection of sheep, cattle, and goats. The virus causes relatively high mortalities in newborn lambs and kids, subclinical infection in adult animals, occasional abortion in ewes, congenital malformations of the central nervous system accompanied by arthrogryposis of the ovine and bovine foetus, and hydrops amnii in ewes. In humans it causes a non-fatal influenza-like illness.
The history of WSL in southern Africa is interwoven with that of Rift Valley fever (RVF), and this has had a marked influence on the manner in which the disease is perceived. In 1955 neonatal deaths and abortions occurred in a flock of sheep in the Wesselsbron district of the Free State in South Africa on a farm where pregnant sheep had been inoculated with RVF vaccine two weeks previously. It was feared that the problem was associated with the use of the vaccine, but a new virus, named after the district of its origin, was isolated from the brain and liver of an eight-day-old lamb.95 Within a month, the same virus was isolated from the blood of a febrile field worker employed by a medical team that was investigating arthropod-borne viruses in the northern part of KwaZulu-Natal, and from mosquitoes.78 The virus was also isolated from a lamb in the Kroonstad district, close to Wesselsbron, in 1957. Transmission by mosquitoes was soon demonstrated experimentally,66 and the new agent was identified as a flavivirus.18, 78
In 1956 and 1957 outbreaks of WSL complicated by geeldikkop, a hepatotoxic poisoning associated with the plant Tribulus terrestris,49, 88 and enzootic icterus, a chronic form of copper poisoning,13 occurred on three farms in the Middelburg district of the Northern Cape Province.14, 58 During these outbreaks WSL virus (WSLV) was isolated from the tissues of a number of sheep as well as from mosquitoes and an entomologist.39, 56
In South Africa, the virus was subsequently isolated from a moribund cow in KwaZulu-Natal in 1973,63 the organs of two calves in 1974 and 1975 in the Mpumalanga and Gauteng provinces,20 two new-born lambs in 1975 in the central Free State,24 two lambs in 1988 (one animal originating from Upington in the Northern Cape Province and the other from Clocolaan in the eastern Free State), a lamb in 1994, and mosquitoes and lambs in 1996 (both the latter two incidents occurring in the Free State).20, 45, 89
In Zimbabwe, WSLV was isolated from wild-caught mosquitoes during the 1969–70 RVF epidemic and from the organs of a cow that had died during an epidemic of RVF in 1978.15 There have been several isolations of the virus from mosquitoes, humans and a camel in West Africa and from mosquitoes in Thailand.74, 80
It is widely accepted that WSLV infection constitutes an important disease of sheep in South Africa, but this assessment is not supported by published and field evidence, nor has a livestock disease problem attributable to this virus been identified elsewhere in Africa. On the other hand, misuse of the modified live (attenuated) vaccine in pregnant sheep has resulted in significant economic losses as a result of abortions and foetal malformations.81
Aetiology
The WSLV has not been well characterized, but it has the properties typical of a haemagglutinating flavivirus.71 The investigations which proved that it was a new flavivirus18, 78 were performed with the second strain (H177) to be isolated, which originated from the blood of a laboratory field worker in 1955.78 Consequently, strain H177 has been widely regarded as the prototype of WSLV84 rather than the original Van Tonder strain.95 Strain YM310,72 isolated from a mixed pool of aedine mosquitoes in Cameroon in 1966, showed quantitative differences in cross-serological tests with WSLV and is regarded as a subtype of the virus.72 Evidence that WSL, yellow fever, Banzi and Uganda S viruses form a close antigenic group or complex within the flaviviruses15, 37, 79, 84 has not been apparent in all studies.12, 26 Full polyprotein nucleotide phylogenetic analysis has shown that WSLV belongs to the yellow fever group, together with Yellow fever virus, Sepik virus and a recently discovered virus named Fitzroy River virus.43, 51
Primary isolation of WSLV is most easily achieved by the use of mice. Similar titres are reached when the virus is titrated by intracerebral or intraperitoneal inoculation of new-born mice or intracerebral inoculation of weaned mice, but mice over three weeks of age are resistant to intraperitoneal infection.12, 95 Hamsters develop viraemia after the subcutaneous inoculation of virus.63 Titration of virus infectivity and demonstration of virus neutralization have been performed most frequently by intracerebral inoculation of new-born or weaned mice, but there is a trend towards using cytopathic effect or plaque formation in cell cultures for these purposes.12, 15, 21, 25, 26, 48, 80, 91 The virus replicates with cytopathic effects or formation of plaques in a variety of cell cultures including Vero and baby hamster kidney-cell lines and primary lamb kidney cells.15, 48, 95
Epidemiology
Wesselsbron virus has been isolated from vertebrates or arthropods in South Africa, Zimbabwe, Uganda, Kenya, Nigeria, the Central African Republic, Senegal, Cameroon, Ivory Coast, Mauritania and Thailand.28, 65, 81 In addition, the results of antibody surveys provide evidence for the occurrence of the virus in Mozambique, Botswana, Namibia, Angola and possibly Madagascar.81 Information is lacking for many countries in Africa, but from the distribution of the aedine mosquitoes associated with WSLV it can be surmised that the virus occurs more widely than is at present realized.
Wesselsbron virus is most pathogenic for new-born lambs, kids and pregnant ewes21, 24, 94 and causes subclinical infections in non-pregnant adult sheep, goats, cattle, horses and pigs.22, 94, 95 Apart from humans, sheep, goats and cattle and a camel, the only other mammal from which WSLV has been isolated was a Namaqua gerbil (Desmodillus auricularis) and a black rat (Rattus rattus).27, 63 The virus has also been isolated from ostrich chicks, although it is uncertain whether it was responsible for disease in the chicks, and at least one isolate was subsequently found to be West Nile virus (WNV).2, 17 Several other rodent species appear to be refractory to WSLV.7, 63 Antibodies to WSLV have been found in wild herbivores in southern Africa.10 The only isolation made from a domestic animal outside South Africa and Zimbabwe was from the blood of a camel tested during a routine survey in Nigeria.50 Human infections occur most frequently in laboratory workers. It was suggested that infected migrating birds may play a role in disseminating WSLV from areas where it is endemic,38 but the available evidence indicates that birds are refractory to the virus.7, 12, 63
Wesselsbron virus has been isolated from several wild caught mosquito species, mainly floodwater breeding Aedes spp., in southern Africa (Table 1). The 1957 isolations in South Africa (Table 1) were made during an apparent outbreak of WSL in sheep56 and the virus was also isolated from mosquitoes during the 1969–70 epidemic of RVF in Zimbabwe.7, 60, 63 All other isolations from arthropods appear to have been made in the course of routine surveys. An isolation of WSLV from an ixodid tick (Rhipicephalus muhsamae)7 is potentially of epidemiological importance. Transstadial infection has been demonstrated in the argasid tick (Ornithodoros savignyi), but transmission tests were negative.46 The available information indicates that floodwater breeding Aedes spp. mosquitoes of the subgenera Ochlerotatus and Neomelaniconion, especially Aedes (Neo.) circumluteolus and Ae. (Och.) caballus s.l., are the principal vectors of the virus in southern Africa.53, 66, 81 It seems feasible that mechanical transmission by biting flies can occur during epidemics, as is suggested to be the case in RVF.40
The intensity of viraemia attained in lambs is sufficient to infect mosquitoes53 and it can be deduced that the same is probably true for other domestic ruminants and rodents. The high prevalence of antibody to WSLV in domestic ruminants in parts of southern Africa suggests that livestock may play a significant role in the maintenance of the virus.81 Serological surveys in wild vertebrates have been too limited to allow any conclusions to be drawn on their role in the epidemiology of the disease.
Antibodies to WSLV are most prevalent in domestic ruminants in the warmer and wetter parts of southern Africa, namely South Africa’s northern KwaZulu-Natal Province, Mozambique and Zimbabwe, all of which are largely cattle-farming areas.54, 55, 75, 76, 77, 81, 82, 95 On the drier and more temperate inland plateau of South Africa, where sheep farming predominates, antibody to WSLV is less common and WNV is the dominant flavivirus.29, 64
The high prevalence of antibodies to WSLV in northern KwaZulu-Natal, Mozambique and Zimbabwe suggests that there is a high prevalence of infection. Serial monitoring of cattle in Zimbabwe indicated that at least one-eighth of all cattle became infected each year.15 Moreover, in the absence of harsh winters, infection appears to occur throughout the year.15 In these endemic or hyper-endemic areas, therefore, most animals are probably immune by the time that they are bred and so do not suffer abortifacient or teratogenic consequences during pregnancy and are able to confer maternal immunity on their offspring. Furthermore, since infections occur virtually throughout the year, there is unlikely to be a sudden upsurge of primary infections at a critical stage of the livestock breeding cycle. In summary, WSLV infection is common, but the disease is rarely recognized in what can be described as endemically stable areas.
On the inland plateau of South Africa, where the Ae. (Och.) caballus-juppi group replaces Ae. (Neo.) circumluteolus of KwaZulu-Natal and Mozambique as the main mosquito vectors of the virus, the drier conditions and winter frosts dictate that outbreaks of WSLV infection are irregular, short-lived and dependent on episodes of heavy rain.63 The abundance of rainfall in South Africa appears to follow a 20- year cycle,87 and consequently outbreaks of RVF and WSLV infection have been diagnosed at irregular intervals of years when abnormally heavy rains favour the floodwater breeding mosquitoes. The infrequent surges of challenge rate, the lower prevalence of immunity and the innate susceptibility of sheep which predominate on the inland plateau, create conditions favouring the occurrence of periodic outbreaks of infection and disease in this area. Infection is thus more infrequent, but disease is more readily apparent than in the hyper-endemic areas. The outbreaks are usually recognized well into the wet season, in late summer and autumn, and are terminated sharply by the first frosts of winter. In exceptionally wet years, outbreaks may persist throughout the winter as occurred in 1974–75.11
Table 1 Summary of isolations of Wesselsbron virus from wild-caught arthropods in southern Africa from 1955 to 1996
| ARTHROPOD | ISOLATIONS | COUNTRY | RERERENCES |
|---|---|---|---|
| Aedes (Neo.) circumluteolus | 13 | South Africa | 7, 63, 78, 96 |
| Ae. (Neo.) lineatopennis* | 3 | South Africa | 56 |
| Ae. (Neo.) albothorax** | – | – | – |
| Ae. (Neo.) lineatopennis* | 15*** | Zimbabwe | 7, 60, 63 |
| Ae. (Och.) caballus sensu lato**** | 13 | South Africa | 56 |
| Ae. (Adm.) minutus | 1 | South Africa | South Africa |
| Ae. (Adm.) veeniae | 1 | South Africa | 7 |
| Mansonia (Man.) uniformis | 1 | South Africa | 56, 63, 64 |
| Culex (Cux.) univittatus***** | 1 | South Africa | 56, 97 |
| Ae. (Neo.) mcintoshi/luridus | 5 | South Africa | 45 |
| Ae. (Och.) juppi/caballus | 5 | South Africa | 45 |
* Ae. (Neo.) mcintoshi41
** Probably Ae. (Neo.) luridus63
*** 17 isolations reported in one publication but 15 elsewhere7, 60, 63
**** Could be Ae. (Och.) caballus sensu stricta or Ae. (Och.) juppi61
***** Cx. (Cux.) neavei44
In Kenya, there appears to be a similar pattern of distribution to that in South Africa with antibodies to WSLV in animals common at the coast and antibodies to WNV predominating in the interior.36, 38, 69 Antibodies to WSLV was found to be more common than antibodies to other flaviviruses in Uganda, the Zambezi region of Namibia and parts of Angola.52, 57 Elsewhere in Africa, antibodies to West Nile, yellow fever, dengue and Zika viruses were generally more common than antibodies to WSLV, despite the fact that there have been multiple isolations of WSLV in West Africa.8, 19, 27, 30, 31, 32, 33, 34, 42, 57, 68, 69, 70 It has been suggested that immunity to other flaviviruses may modify WSLV infection in livestock,35 but it is possible that some of the flaviviruses are themselves pathogenic.81
By analogy with the mechanism proposed for RVF,1, 59 it is possible that WSLV may overwinter and be perpetuated by transovarial transmission in floodwater breeding aedine mosquito vectors, although transovarial transmission has not been demonstrated.81 Such a mechanism would seem to be particularly necessary on the inland plateau of South Africa where harsh winters suppress adult mosquito activity. Eggs of floodwater breeding aedines can withstand the long periods of desiccation, which occur between periods of heavy rainfall on the plateau.
Virus activity appears to occur all year round in the warmer and moister parts of southern Africa such as Zimbabwe, KwaZulu-Natal and Mozambique, so theoretically, no special mechanism is required for over-wintering and perpetuation of the virus in such areas.
Humans in South Africa appear to have become infected by mosquitoes in the field,6, 39, 62, 78 after performing necropsies on infected animals,39 or merely from handling infected tissues or cultures in the laboratory.95 Aerosol transmission may also be possible.3, 16, 47, 86
Despite the evidence that laboratory workers gained infection by handling infected tissues and cultures, or from aerosols, it does not appear that WSLV is contagious between sheep.24, 95
Pathogenesis
A few pathogenicity studies have been performed with WSLV in laboratory and domestic animals but, apart from the teratological effects, the mechanisms of pathogenesis are poorly understood.9, 21, 23, 24, 93 The virus possesses hepato- and neurotropic properties and is highly neuro-invasive in the ovine foetus.24, 67, 93 It appears that WSL disease and RVF share many clinical and pathological features, suggesting that the pathogenesis of the two disorders are similar (see Rift Valley fever), although there are also distinct differences. Wesselsbron disease is usually milder and less peracute than RVF, as is shown by the much lower mortality and abortion rates in domestic ruminants, and the presence of icterus and less widespread destructive hepatic lesions. Haemorrhagic tendencies as manifested by mucosal haemorrhages and free blood in the abomasum of neonates are features of both diseases. Wesselsbron virus appears to be more neurotropic than RVF virus as severe teratology of the central nervous system of the foetus results if sheep or cattle are inoculated with the wild-type or attenuated vaccine WSL viruses during early and mid-pregnancy.21, 23
Clinical signs
In new-born lambs, the incubation period of one to three days is followed by non-specific signs of illness including fever (which is often biphasic), anorexia, listlessness, weakness and increased respiratory rate, the respiration being mostly abdominal.24, 95 Death may supervene within 72 hours of infection. A mortality rate of 27 per cent was reported in experimental infection of one- to three-day-old lambs.24 In newborn goat kids inoculated with the virus, the clinical signs were similar to those in newborn lambs and the mortality rate was about 18 per cent.24
In general, WSL in calves and adult sheep, goats and cattle is a non-fatal, febrile and clinically inapparent infection. The incubation period is two to five days.20, 21
The outcome of infection in pregnant animals is dependent upon the stage of pregnancy. Following experimental infection in late pregnancy, some ewes aborted within a few days as a consequence of fever and it was not possible to detect WSLV in the foetuses.95 Abortion that occurs about five days after incubation is associated with infection of the foetus. Nevertheless, isolation of WSLV has never been reported from specimens of an aborted foetus from the field.15, 81 Experimental WSLV infection may cause embryonic death and unnoticed loss of the conceptus in very early pregnancy possibly as a result of resorption.21 Later in pregnancy, foetal death may result in overt abortion, or in retention and mummification of the foetus.15 It has been shown experimentally that wild and attenuated vaccine WSL viruses are capable of producing hydrops amnii and prolonged gestation in ewes in association with porencephaly or hydranencephaly and arthrogryposis in their foetuses or lambs21 if infection occurs between 45 and 90 days of gestation. The wild WSLV produced porencephaly and cerebellar hypoplasia when inoculated directly into a bovine foetus at 115 days of pregnancy.23
In humans the incubation period of WSLV infection ranges from two to seven days. Onset of disease is marked by the sudden appearance of fever, rigors, severe headache, tachycardia, anorexia, myalgia and arthralgia. Retro-orbital pain is commonly experienced and some patients suffer photophobia and temporary loss of visual acuity. Cutaneous hyperaesthesia of the trunk, arms or scalp and a rash over the trunk have also been reported. Hepatomegaly or hepatosplenomegaly occurs in some patients in association with tenderness of the abdomen, and occasionally with raised serum alanine and aspartate transaminase levels. Most patients recover from the acute illness in one to three days and then suffer mild lassitude over a convalescence period of about a week.3, 4, 7, 16, 39, 47, 62, 78, 86, 95 A patient who became infected by splashing virus suspension into his eye was severely ill with marked symptoms of encephalitis, including severe headaches, deafness, slurred speech, loss of memory, incoordination and muscular spasms.92
Pathology
At necropsy, most diseased new-born lambs and kids have moderate to severe icterus (Figure 1), and slight to moderate hepatomegaly, the liver being yellowish to orange-brown and sometimes mottled with congested patches (Figure 2).24 Petechiae and ecchymoses are commonly found in the mucosa of the abomasum, the content of which often has a distinct chocolate-brown colour as a result of partially digested blood. All lymph nodes are slightly swollen and congested. Histopathological examination of the liver reveals mild to extensive necrosis of the parenchyma; individual or small groups of necrotic hepatocytes are scattered throughout the lobules (Figure 3). Apart from the necrotic hepatocytes, most other liver cells reveal cloudy swelling and hydropic degeneration. Other changes in the liver include mild to moderate Kupffer cell proliferation, cholestasis, mild to moderate proliferation of bile ductules, and infiltration of mononuclear cells, particularly histiocytes, in the portal triads.24 Intranuclear inclusion bodies that stain eosinophilically in haematoxylin and eosin tissue sections, and which are inconsistent in shape and size are present in some necrotic hepatocytes. Pyknosis and karyorrhexis of lymphocytes are usually noticed in the spleen and lymph nodes.24
Although no macroscopic lesions were noticed in the liver of experimentally infected adult sheep and goats killed for necropsy, histopathological examination revealed only a few small, multiple foci of hepatocytic necrosis, mild Kupffer cell proliferation, a few retrothelial nodules (Figure 4) and mild mononuclear infiltration of the portal triads.22
Experimental infection of sheep with WSLV suggested that the ovine placenta was a primary target organ of WSLV. It appeared that WSLV first replicated in maternal epithelial cells, before infection of foetal trophoblasts in the foetal part of the placenta. Spread of the virus to the foetus showed WSLV was not only present in the liver and sporadically in foetal striated muscle fibre and osteoblasts, but was also highly neurotropic and neuroinvasive, with foetal neurons the primary target cell.67
Two calves that died of the disease showed severe icterus, marked hepatomegaly and splenomegaly, greyish-brown discoloration of the liver, and numerous petechiae and ecchymoses in the serosal surfaces of the gall bladder and viscera, and epi- and endocardium. The microscopic lesions in the liver were very similar to those reported in newborn lambs.20
Diagnosis
The history and epidemiology of the disease, including a relatively high mortality rate in newborn lambs and kids, and climatological conditions which favour the occurrence of large populations of mosquito vectors should warn of the possible presence of WSL disease. In newborn lambs the macroscopic and, particularly, the microscopic lesions in the liver are often sufficient to make a diagnosis of WSL disease.
During the acute stage of infection or disease, virus may be isolated from a variety of tissues, including blood, liver, spleen, adrenals, brain, lungs, kidneys and lymph nodes.85
Intracerebral inoculation of newborn mice is the best method for isolating WSLV, and the lack of susceptibility of weaned mice to intraperitoneal infection forms the basis of a convenient screening test to distinguish WSLV from RVF virus when the two viruses are encountered together.95 Cell cultures, used together with immunofluorescence, would probably constitute a rapid method for the isolation and identification of WSLV.
Serodiagnosis of WSLV infection has invariably been based on ELISA, haemagglutination inhibition (HAI), complement fixation (CF) and virus neutralization VN test.73 In experimental WSL infections of sheep and cattle, antibody became demonstrable by HAI and VN techniques four days after infection at the earliest, and maximum titres were attained one to three weeks after infection. Haemagglutination inhibition antibody titres declined to undetectable levels in 25 months, while minimal VN titres remained detectable at this stage. Complement fixation antibody became demonstrable ten days after infection at the earliest and was undetectable 12 weeks after infection.81
Cross-reactivity with other flaviviruses is marked in HAI tests but is less evident in CF and VN test.18, 81 Nevertheless, homologous WSLV titres greatly exceed heterologous flavivirus titres following primary WSLV infection and can be distinguished with ease by the performance of quantitative HAI, CF or VN test with a range of flaviviruses known to occur in the region concerned.81 More reliance may be placed on VN test for distinguishing antibodies to individual viruses, but it is well known that antibody cross-reactivity may be so marked following sequential infection with two or more flaviviruses that it is no longer possible to make a diagnosis with confidence, even by performing quantitative VN tests.18, 83
A multiplex, genus-specific high-resolution melting analysis RT-PCR assay for WSLV and other arboviruses has been described.90
Establishing an aetiological diagnosis in an outbreak of teratology in livestock can be difficult.
Differential diagnosis
Wesselsbron disease, particularly in newborn lambs and kids, has in the past often been confused with RVF. For differentiation of the two diseases, consult the chapter on RVF.
Other flaviviruses and unrelated viruses are capable of producing similar congenital defects in sheep and cattle to WSLV.12
Control
Immunization of sheep and goats with attenuated WSL vaccine is the only effective method of control. Wesselsbron disease vaccine is prepared from a strain of virus attenuated by 145 serial intracerebral passages in newborn mice. The attenuated virus is grown in BHK21 cells and freeze-dried.5, 21 The vaccine is sold for use in non-pregnant sheep and goats in winter or early spring. Wesselsbron disease is not known to be a serious problem in cattle and they are not usually vaccinated. Immunity following vaccination is life-long, so revaccination is not recommended. There is no vaccine for humans, nor does the available evidence suggest that there is a need for such vaccine.
General recommendations made to farmers concerning the control of WSL and other arthropod-borne infections of livestock include drainage or treatment of mosquito breeding sites (see Vectors: Mosquitoes), housing of sheep at night when mosquitoes and midges are most active, and the moving of stock away from low-lying, poorly drained areas to high, wind-swept grazing where biting arthropods are usually less prevalent.
References
- ALEXANDER, R. A., 1957. Discussion on both Rift Valley fever (RVF) and Wesselsbron virus disease (WVD). Proceedings of the Fourth Meeting of the Inter-African Advisory Committee on Epizootic Diseases, 10-11 May, 1957, Dakar.
- ALLWRIGHT, D. M., GEYER, A., BURGER, W. P., WILLIAMS, R., GERDES, G. H. & BARNARD, B. J., 1995. Isolation of Wesselsbron virus from ostriches. Veterinary Record, 136, 99.
- ANON., 1974. Annual Report of the Institut Pasteur, Bangui, Central African Republic.
- ANON., 1976. Rapport sur le fonctionnement technique de l’Institut Pasteur de Dakar, Senegal, Années, 1974-1976.
- ANON., 1985. Annual Reports of the Institut Pasteur, Dakar, Senegal, 1982-1985.
- ANON., 1985. Annual Reports, Director, Veterinary Research Institute, Onderstepoort, South Africa, 1953-1985.
- ANON., 1985. Arbovirus Research Unit, National Institute for Virology, Sandringham, South Africa, Unpublished Records, 1953-1985.
- ARDOIN, P., RODHAIN, F. & HANNOUN, C., 1976. Epidemiologic study of arboviruses in the Arba-Minch district of Ethiopia. Tropical and Geographical Medicine, 28, 309-315.
- BABA, S. S., 1993. Virological and immunological studies of Wesselsbron virus in experimentally infected red Sokoto (Maradi) goats. Veterinary Microbiology, 34, 311-320.
- BARNARD, B. J., 1997. Antibodies against some viruses of domestic animals in southern African wild animals. Onderstepoort Journal of Veterinary Research, 64, 95-110.
- BARNARD, B. J. H., 1981. Rift Valley fever in South Africa. Proceedings of the Forty-ninth General Session of the Office International des Epizooties, Paris.
- BARNARD, B. J. H. & VOGES, S. F., 2002. Flaviviruses in South Africa: diagnostic procedures. Onderstepoort Journal of Veterinary Research, 53, 181-185.
- BATH, G. F., 1979. Enzootic icterus—a form of copper poisoning. Journal of the South African Veterinary Association, 50, 3-14.
- BELONJE, C. W. A., 1958. Field observations on Wesselsbron disease. Journal of the South African Veterinary Medical Association, 29, 1-12.
- BLACKBURN, N. K. & SWANEPOEL, R., 1980. An investigation of flavivirus infections of cattle in Zimbabwe Rhodesia with particular reference to Wesselsbron virus. Journal of Hygiene, 85, 1-33.
- BRÉS, P., 1965. [Human infection with Wesselsbron virus caused by laboratory contamination (authors’ translation)]. Bulletin de la Societe de Pathologie Exotique et de Ses Filiales, 58, 994-999.
- BURT, F. J., GROBBELAAR, A. A., LEMAN, P. A., ANTHONY, F. S. & GIBSON, G. V. S., 2002. Phylogenetic relationships of southern African West Nile isolates. Emerging Infectious Diseases, 8, 820-826.
- CASALS, J., 1957. Viruses: The versatile parasites: I. The arthropod-borne group of animal viruses. Transactions of the New York Academy of Sciences, 19, 219-235.
- CHIPPAUX, A., CHIPPAUX-HYPPOLITE, C., MONTENY-VANDERVORST, N. & SOULOUMIAC-DEPREZ, D., 1981. [Several yellow fever cases in an endemic area in Ivory Coast: Serological and epidemiological evidence (authors’ translation)]. Medicine Tropicale, 41, 53-61.
- COETZER, J. A. W., 1990. Unpublished observations. Faculty of Veterinary Science, University of Pretoria.
- COETZER, J. A. W. & BARNARD, B. J. H., 1977. Hydrops amnii in sheep associated with hydranencephaly and arthrogryposis with Wesselsbron disease and Rift Valley fever viruses as aetiological agents. Onderstepoort Journal of Veterinary Research, 44, 119-126.
- COETZER, J. A. W. & THEODORIDIS, A., 1982. Clinical and pathological studies in adult sheep and goats experimentally infected with Wesselsbron disease virus. Onderstepoort Journal of Veterinary Research, 49, 19-22.
- COETZER, J. A. W., THEODORIDIS, A., HERR, S. & KRITZINGER, L., 1979. Wesselsbron disease: A cause of congenital porencephaly and cerebellar hypoplasia in calves. Onderstepoort Journal of Veterinary Research, 46, 165-169.
- COETZER, J. A. W., THEODORIDIS, A. & VAN HEERDEN, A., 1978. Wesselsbron disease. Pathological haematological and clinical studies in natural cases and experimentally infected new-born lambs. Onderstepoort Journal of Veterinary Research, 45, 93-106.
- DE MADRID, A. T. & PORTERFIELD, J. S., 1969. A simple micro-culture method for the study of Group B arboviruses. Bulletin of the World Health Organization, 40, 113-121.
- DE MADRID, A. T. & PORTERFIELD, J. S., 1974. The flaviviruses (Group B arboviruses): A cross neutralization study. Journal of General Virology, 23, 91-96.
- DIAGNE, M. M., FAYE, M., FAYE, O., SOW, A., BALIQUE, F., SEMBÈNE, M., GRANJON, L., HANDSCHUMACHER, P., FAYE, O., DIALLO, M. & SALL, A. A., 2017. Emergence of Wesselsbron virus among black rat and humans in Eastern Senegal in 2013. One Health, 3, 23-28.
- DIALLO, M., NABETH, P., BA, K., SALL, A. A., BA, Y., MONDO, M., GIRAULT, L., ABDALAHI, M. O. & MATHIOT, C., 2005. Mosquito vectors of the 1998-1999 outbreak of Rift Valley Fever and other arboviruses (Bagaza, Sanar, Wesselsbron and West Nile) in Mauritania and Senegal. Medical and Veterinary Entomology, 19, 119-126.
- DICKINSON, D. B., MCGILLIVRAY, G. M., MCINTOSH, B. M. & WINTER, P. A. D., 1965. Antibodies against certain arboviruses in sera from human beings and domestic animals from the south-western and north-western regions of the Cape Province of South Africa. South African Journal of Medical Science, 30, 11-18.
- FAGBAMI, A., 1977. Epidemiological investigations on arbovirus infections at Igbo-Ora, Nigeria. Tropical and Geographical Medicine, 29, 187-191.
- FAGBAMI, A., 1978. Human arthropod-borne virus infections in Nigeria. Serological and virological investigations and Shaki, Oyo State. Journal of Hygiene, Epidemiology, Microbiology and Immunology, 22, 184-189.
- FAGBAMI, A. H., 1979. Zika virus infections in Nigeria: Virological and seroepidemiological investigations in Oyo State. Journal of Hygiene, 83, 213-219.
- FAGBAMI, A. H. & FABIYI, A., 1975. Arbovirus studies in two towns in the western state of Nigeria. Tropical and Geographical Medicine, 27, 59-62.
- FAGBAMI, A. H., MONATH, T. P. & FABIYI, A., 1977. Dengue virus infections in Nigeria: A survey for antibodies in monkeys and humans. Transactions of the Royal Society of Tropical Medicine and Hygiene, 71, 60-65.
- FAGBAMI, A. H. & OJEH, C., 1981. Wesselsbron virus infection in West African dwarf sheep: Effect of pre-infection serum flavivirus antibodies on severity of disease. Veterinary Microbiology, 6, 287-293.
- GESER, A., HENDERSON, B. E. & CHRISTENSEN, S., 1970. A multipurpose serological survey in Kenya. Bulletin of the World Health Organization, 43, 539-552.
- HENDERSON, B. E., CHESHIRE, P. P., KIRYA, G. B. & LULE, M., 1970. Immunologic studies with yellow fever and selected African group B arboviruses in rhesus and vervet monkeys. American Journal of Tropical Medicine and Hygiene, 19, 110-118.
- HENDERSON, B. E., METSELAAR, D., KIRYA, G. B. & TIMMS, G. L., 1970. Investigations into yellow fever virus and other arboviruses in northern regions of Kenya. Bulletin of the World Health Organization, 42, 787-795.
- HEYMANN, C. S., KOKERNOT, R. H. & DE MEILLON, B., 1958. Wesselsbron virus infections in man. South African Medical Journal, 32, 543-545.
- HOCH, A. L., GARGAN, T. P. & BAILEY, C. L., 1985. Mechanical transmission of Rift Valley fever virus by hematophagous Diptera. American Journal of Tropical Medicine and Hygiene, 34, 188-193.
- HUANG, Y. M., 1985. A new African species of Aedes (Diptera: Culicidae). Mosquito Systematics, 17, 108-120.
- JAN, C., LANGUILLAT, G., RENAUDET, J. & ROBIN, Y., 1978. [A serological survey of arboviruses in Gabon (authors’ translation)]. Bulletin de la Societe de Pathologie Exotique et de Ses Filiales, 71, 140-146.
- JOHANSEN, C. A., WILLIAMS, S. H., MELVILLE, L. F., NICHOLSON, J., HALL, R. A., BIELEFELDT-OHMANN, H., PROW, N. A., CHIDLOW, G. R., WONG, S., SINHA, R., WILLIAMS, D. T., LIPKIN, W. I. & SMITH, D. W., 2017. Characterization of Fitzroy River Virus and Serologic Evidence of Human and Animal Infection. Emerging Infectious Diseases, 23, 1289-1299.
- JUPP, P. G., 1971. The taxonomic status of Culex (Culex) univittatus Theobald (Diptera: Culicidae) in South Africa. Journal of the Entomological Society of South Africa, 34, 339-357.
- JUPP, P. G. & KEMP, A., 1998. Studies on an outbreak of Wesselsbron virus in the Free State Province, South Africa. Journal of the American Mosquito Control Association, 14, 40-45
- JUPP, P. G. & MCINTOSH, B. M., 1981. Ticks and arthropod-borne viruses in South Africa. Proceedings of the International Conference on Tick Biology and Control. Tick Research Unit, Rhodes University, Grahamstown, 27–29 January 1981, 177-180.
- JUSTINES, G. A. & SHOPE, R. E., 1969. Wesselsbron virus infection in a laboratory worker, with virus recovery from a throat washing. Health Laboratory Science, 6, 46-49.
- KARABATSOS, N. & BUCKLEY, S. M., 1967. Susceptibility of the baby hamster kidney cell line (BHK-21) to infection with arboviruses. American Journal of Tropical Medicine and Hygiene, 16, 99-105.
- KELLERMAN, T. S., COETZER, J. A. W. & NAUDE, T. W., 1988. Plant Poisonings and Mycotoxicoses of Livestock in Southern Africa. Journal of the South African Veterinary Association. Cape Town: Oxford University Press Southern Africa.
- KEMP, G. E., CAUSEY, O. R., MOORE, D. L. & O’CONNOR, E. H., 1973. Viral isolates from livestock in northern Nigeria: 1966–1970. American Journal of Veterinary Research, 34, 707-710.
- KING, A. M. Q., ADAMS, M. J., CARSTENS, E. B. & LEFKOWITZ, E. J., 2012. Virus taxonomy: classification and nomenclature of viruses: ninth report of the International Committee on Taxonomy of Viruses. London: Academic Press.
- KOKERNOT, R. H., CASACA, V. M. R., WEINBREN, M. P. & MCINTOSH, B. M., 1965. Survey for antibodies against arthropod-borne viruses in the sera of indigenous residents of Angola. Transactions of the Royal Society of Tropical Medicine and Hygiene, 59, 563-570.
- KOKERNOT, R. H., PATERSON, H. E. & DE MEILLON, B., 1958. Studies on the transmission of Wesselsbron virus by Aedes (Oclerotatus) caballus (Theo.). South African Medical Journal, 32, 546-549.
- KOKERNOT, R. H., SMITHBURN, K. C., GANDARA, A. F., MCINTOSH, B. M. & HEYMANN, C. S., 1960. Provas de neutralizaçao com soros de indivíduos residentes em Moçambique contra determinados vírus isolados em Africa transmitidos por artrópodes. Anals Do Instituto De Medicino Tropical, 17, 201-230.
- KOKERNOT, R. H., SMITHBURN, K. C. & KLUGE, F., 1961. Neutralizing antibodies against arthropod-borne viruses in the sera of domestic quadrupeds ranging in Tongaland, Union of South Africa. Annals of Tropical Medicine and Parasitology, 55, 73-85.
- KOKERNOT, R. H., SMITHBURN, K. C., PATERSON, H. E. & DE MEILLON, B., 1960. Further isolations of Wesselsbron virus from mosquitoes. South African Medical Journal, October, 871-874.
- KOKERNOT, R. H., SZLAMP, E. L., LEVITT, J. & MCINTOSH, B. M., 1965. Surveys for antibodies against arthropod-borne viruses in the sera of indigenous residents of the Caprivi Strip and Bechuanaland Protectorate. Transactions of the Royal Society of Tropical Medicine and Hygiene, 59, 553-562.
- LE ROUX, J. M. W., 1959. The histopathology of Wesselsbron disease in sheep. Onderstepoort Journal of Veterinary Research, 28, 237-243.
- LINTHICUM, K. J., DAVIES, F. G., KAIRO, A. & BAILEY, C. L., 1985. Rift Valley fever virus (family Bunyaviridae, genus Phlebovirus). Isolations from Diptera collected during an inter-epizootic period in Kenya. Journal of Hygiene, Cambridge, 95, 197-209.
- MCINTOSH, B. M., 1972. Rift Valley fever: I. Vector studies in the field. Journal of the South African Veterinary Association, 43, 391-395.
- MCINTOSH, B. M., 1973. A taxonomic reassessment of Aedes (Ochlerotatus) caballus (Theobald) (Diptera: Culicidae) including a description of a new species of Ochlerotatus. Journal of the Entomological Society of Southern Africa, 36, 261-269.
- MCINTOSH, B. M., 1980. The epidemiology of arthropod-borne viruses in southern Africa. D.Sc. Thesis, University of Pretoria.
- MCINTOSH, B. M., 1980. The epidemiology of arthropod-borne viruses in Southern Africa. DSc Thesis, University of Pretoria.
- MCINTOSH, B. M., DICKENSON, D. B. & SERAFINI, E. T., 1962. Antibodies against certain arboviruses in sera from human beings and domestic animals from the South African Highveld. South African Journal of Medical Sciences, 27, 87-94.
- MUSHI, E. Z., BINTA, M. G. & RABOROKGWE, M., 1998. Wesselsbron disease virus associated with abortions in goats in Botswana. Journal of Veterinary Diagnostic Investigation, 10, 191.
- MUSPRATT, J., SMITHBURN, K. C., PATHMANATHAN, R. & KOKERNOT, R. H., 1957. Studies on artropod-borne viruses of Tongaland. X. The laboratory transmission of Wesselsbron virus by the bite of Aedes (Banksinella) circumluteolus (Theo.). South African Journal of Medical Science, 22, 121-126.
- OYMANS, J., VAN KEULEN, L., WICHGERS SCHREUR, P. J. & KORTEKAAS, J., 2020. Early Pathogenesis of Wesselsbron Disease in Pregnant Ewes. Pathogens, 9, 373.
- RENAUDET, J., JAN, C., RIDET, J., ADAM, C. & ROBIN, Y., 1978. [A serological survey of arboviruses in the human population of Senegal (authors’ translation)]. Bulletin de la Societe de Pathologie Exotique et de Ses Filiales, 71, 131-140.
- RODHAIN, F., ARDOIN, P., METSELAAR, D., SALMON, A. M. & HANNOUN, C., 1975. An epidemiologic and serologic study of arboviruses in Lake Rudolf basin. Tropical and Geographical Medicine, 27, 307-312.
- RODHAIN, R., HANNOUN, C. & METSELAAR, D., 1972. Enquete epidemiologique et serologique sur les arboviroses dans la basse valle de l’Omo (Ethiopie meridionale). Bulletin of the World Health Organization, 47, 295-304.
- RUSSEL, P. K., BRANDT, W. E. & DALRYMPLE, J. M., 1980. Chemical and antigenic structure of flaviviruses. In: SCHLESINGER, R. W., (ed.). The Togaviruses. New York: Academic Press.
- SALAÜN, J. J., RICKENBACH, A., BRÉS, P., BROTTES, H., GERMAIN, M., EOUZAN, J. P. & FERRARA, L., 1969. Les arbovirus isolés à partir de moustiques au Cameroun. Bulletin of the World Health Organization, 41, 233-241.
- SHOPE, R. E. & SATHER, G. E., 1979. Arboviruses. In: LENNETTE, E. H. & SCHMIDT, N. J., (eds.). Diagnostic Procedures for Viral, Rickettsial and Chlamydial Infections. 5th edn. Washington D.C.: Public Health Association.
- SIMASATHIEN, P. & OLSON, L. C., 1973. Factors influencing the vector potential of Aedes aegypti and Culex quinquefasciatus for Wesselsbron virus. Journal of Medical Entomology, 10, 587-590.
- SMITHBURN, K. C., 1958. Problems of the artropod-borne viruses in Africa. Annales de Societes de Belges de Medicine Tropicale, 38, 347-358.
- SMITHBURN, K. C. & DE MEILLON, B., 1959. Ecology of certain arthropod-borne viruses of southern Africa. Proceedings of the Sixth International Congresses on Medicine and Malaria, Lisbon, 1958. Annais do Instituo de Medicine Tropical, 16, 21-33.
- SMITHBURN, K. C., KOKERNOT, R. H., HEYMANN, C. S., WEINBREN, M. P. & ZENTKOWSKY, D., 1959. Neutralizing antibodies for certain viruses in the sera of human beings residing in northern Natal. South African Medical Journal, 33, 555-561.
- SMITHBURN, K. C., KOKERNOT, R. H., WEINBREN, M. P. & DE MEILLON, B., 1957. Studies on arthropod-borne viruses of Tongaland. IX. Isolation of Wesselsbron virus from a naturally infected human being and from Aedes (Banksinella) circumluteolus (Theo.). South African Journal of Medical Science, 22, 113-120.
- SMITHBURN, K. C., PATERSON, H. E., HEYMANN, C. S. & WINTER, P. A. D., 1959. An agent related to Uganda S virus from man and mosquitoes in South Africa. South African Medical Journal, 46, 959-962.
- STIM, T. B., 1969. Arbovirus plaquing in two simian kidney cell lines. Journal of General Virology, 5, 329-338.
- SWANEPOEL, R., 1989. Wesselsbron virus disease. In: MONATH, T.P., (ed.). The Arboviruses: Epidemiology and Ecology. Boca Raton: CRC Press, Inc, 1.
- SWANEPOEL, R. & CRUIKSHANK, J. G., 1974. Arthropod-borne viruses of medical importance in Rhodesia. Central African Journal of Medicine, 20, 71-79.
- THEILER, M. & CASALS, J., 1958. The serological reactions in yellow fever. American Journal of Tropical Medicine and Hygiene, 7, 585-594.
- THEILER, M. & DOWNS, W. G., 1973. The Arthropod-borne Viruses of Vertebrates. New Haven and London: Yale University Press.
- THEODORIDIS, A. & COETZER, J. A. W., 1980. Wesselsbron disease: Virological and serological studies in experimentally infected sheep and goats. Onderstepoort Journal of Veterinary Research, 47, 221-229.
- TOMORI, O., MONATH, T. P., O’CONNOR, E. H., LEE, V. H. & CROPP, C. B., 1981. Arbovirus infections among laboratory personnel in Ibadan, Nigeria. American Journal of Tropical Medicine and Hygiene, 30, 855-861.
- TYSON, P. D., 1978. Rainfall changes over South Africa during the period of meteorological record. In: WEGER, M. J. A., (ed.). Biogeography and Ecology of Southern Africa. The Hague: W. Junk.
- VAHRMEIJER, J., 1981. Poisonous Plants of Southern Africa that Cause Stock Losses. Cape Town: Tafelberg.
- VAN DER LUGT, J. J., COETZER, J. A., SMIT, M. M. & CILLIERS, C., 1995. The diagnosis of Wesselsbron disease in a new-born lamb by immunohistochemical staining of viral antigen. Onderstepoort Journal of Veterinary Research, 62, 143-146.
- VILLINGER, J., MBAYA, M. K., OUSO, D., KIPANGA, P. N., LUTOMIAH, J. & MASIGA, D. K., 2016. Arbovirus and insect-specific virus discovery in Kenya by novel six genera multiplex high-resolution melting analysis. Molecular Ecology Resources, 17, 466-480.
- WAY, J. H., BOWEN, E. T. & PLATT, G. S., 1976. Comparative studies of some African arboviruses in cell culture and in mice. Journal of General Virology, 30, 123-130.
- WEINBREN, M. P., 1959. Some clinical observations on a human case of infection with Wesselsbron virus. East African Virus Research Institute Report, July 1958 - June 1959.
- WEISS, K. E., 1957. Rift Valley fever—a review. Bulletin of Epizootic Diseases of Africa, 5, 431-458.
- WEISS, K. E., 1957. Wesselsbron virus disease. Bulletin of Epizootic Diseases of Africa, 5, 459-465.
- WEISS, K. E., HAIG, D. A. & ALEXANDER, R. A., 1956. Wesselsbron virus—a virus not previously described, associated with abortion in domestic animals. Onderstepoort Journal of Veterinary Research, 27, 183-195.
- WORTH, C. B., PATERSON, H. E. & DE MEILLON, B., 1961. The incidence of arthropod-borne viruses in a population of culicine mosquitoes in Tongaland, Union of South Africa (January, 1956, through April, 1960). American Journal of Tropical Medicine and Hygiene, 10, 583-592.
- WORTH, C. P., PATERSON, H. E. & DE MEILLON, B., 1961. The incidence of arthropod-borne viruses in a population of culicine mosquitoes in Tongaland, Union of South Africa. 1956-1960. American Journal of Tropical Medicine and Hygiene, 10, 583-592.